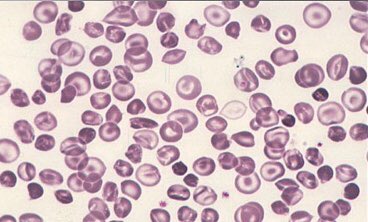
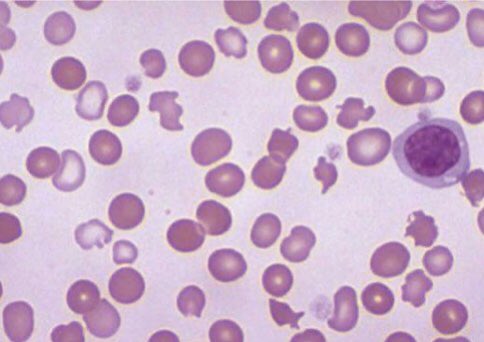

أهلاً بالجميع
ثريد اليوم عن الثلاسيميا
مهم جدا تعرفون وش هو الثلاسيميا أنواعه وأعراضه وطرق الوقاية منه
والاختبارات اللي نسويه بالمختبر
يلا نبدا 😍😍💪🏻
#لاب_زون #مختبرات_طبية
ثريد اليوم عن الثلاسيميا
مهم جدا تعرفون وش هو الثلاسيميا أنواعه وأعراضه وطرق الوقاية منه
والاختبارات اللي نسويه بالمختبر
يلا نبدا 😍😍💪🏻
#لاب_زون #مختبرات_طبية
الأسباب:
تحدث الثلاسيميا بسبب حدوث طفرات في الحمض النووي للخلايا المسؤولة عن إنتاج الهيموغلوبين ـــ وهو مادة في خلايا الدم الحمراء مسؤولة عن حمل الأكسجين في كامل الجسم. تُتوارَث الطفرات المرتبطة بالثلاسيميا من الأهل إلى الأبناء.
تحدث الثلاسيميا بسبب حدوث طفرات في الحمض النووي للخلايا المسؤولة عن إنتاج الهيموغلوبين ـــ وهو مادة في خلايا الدم الحمراء مسؤولة عن حمل الأكسجين في كامل الجسم. تُتوارَث الطفرات المرتبطة بالثلاسيميا من الأهل إلى الأبناء.
- عن حدوث خلل في سلسلة واحدة:
يعد الشخص حاملاً للجين المصاب وبلا أعراض ظاهرة.
- عند حدوث خلل في سلسلتين:
يعاني الشخص الحامل لهذه الجينات من أعراض بسيطة قد لا تظهر ولكن يمكن اكتشافها من خلال فحص الدم
يعد الشخص حاملاً للجين المصاب وبلا أعراض ظاهرة.
- عند حدوث خلل في سلسلتين:
يعاني الشخص الحامل لهذه الجينات من أعراض بسيطة قد لا تظهر ولكن يمكن اكتشافها من خلال فحص الدم
عند حدوث خلل في سلسلتين (الثلاسيميا الكبرى):
يعاني المصاب أعراض فقر دم شديدة وتشوهًا في العظام وتضخمًا في الطحال، ويكون بحاجة إلى نقل الدم بشكل منتظم ليتمكن من الحياة بشكل طبيعي، ولا تظهر هذه الأعراض عند ولادة الطفل؛ ولكن تبدأ في الظهور خلال العامين الأولين من العمر.
يعاني المصاب أعراض فقر دم شديدة وتشوهًا في العظام وتضخمًا في الطحال، ويكون بحاجة إلى نقل الدم بشكل منتظم ليتمكن من الحياة بشكل طبيعي، ولا تظهر هذه الأعراض عند ولادة الطفل؛ ولكن تبدأ في الظهور خلال العامين الأولين من العمر.
الأعراض:
تعتمد على نوع وشدة المرض، فبعض الأطفال تظهر لديهم الأعراض منذ الولادة، في حين أن البعض الآخر تظهر عليهم الأعراض خلال العامين الأولين من العمر، وقد لا تظهر الأعراض لدى الحاملين للمرض (المصابين باضطرابات في جين واحد).
تعتمد على نوع وشدة المرض، فبعض الأطفال تظهر لديهم الأعراض منذ الولادة، في حين أن البعض الآخر تظهر عليهم الأعراض خلال العامين الأولين من العمر، وقد لا تظهر الأعراض لدى الحاملين للمرض (المصابين باضطرابات في جين واحد).
ومن أهم الأعراض:
- الإحساس بالتعب والضعف العام
- شحوب واصفرار في البشرة
- تغير لون البول إلى الداكن
- تأخر في النمو
- ضيق في التنفس
- انتفاخ البطن
- تشوهات في العظام
- التعرض المتكرر للالتهابات
- الإحساس بالتعب والضعف العام
- شحوب واصفرار في البشرة
- تغير لون البول إلى الداكن
- تأخر في النمو
- ضيق في التنفس
- انتفاخ البطن
- تشوهات في العظام
- التعرض المتكرر للالتهابات
المضاعفات:
التعب المستمر
تأخر نمو الطفل وتأخر سن البلوغ
تضخم الطحال وانتفاخ البطن بسبب تكدس الحديد داخل الطحال بدلاً من إعادة استخدامه
نقص حمض الفوليك وفيتامين ب12
تشوه العظام
التعب المستمر
تأخر نمو الطفل وتأخر سن البلوغ
تضخم الطحال وانتفاخ البطن بسبب تكدس الحديد داخل الطحال بدلاً من إعادة استخدامه
نقص حمض الفوليك وفيتامين ب12
تشوه العظام
العلاج
علاج مرض الثلاسيميا يعتمد على نوع الثلاسيميا وشدته، كما أن علاج الحالات المعتدلة إلى الحادة يشمل ما يلي
نقل الدم:
• نقل خلايا الدم الحمراء بطريقة متكررة هي العلاج الرئيس للأشخاص الذين لديهم الثلاسيميا المعتدلة أو الشديدة.
علاج مرض الثلاسيميا يعتمد على نوع الثلاسيميا وشدته، كما أن علاج الحالات المعتدلة إلى الحادة يشمل ما يلي
نقل الدم:
• نقل خلايا الدم الحمراء بطريقة متكررة هي العلاج الرئيس للأشخاص الذين لديهم الثلاسيميا المعتدلة أو الشديدة.
• زرع الخلايا الجذعية (زرع نخاع العظام):
يمكن استخدام عملية زرع الخلايا الجذعية لعلاج الثلاسيميا الشديدة.
• علاج تكدس الحديد:
يقوم الأطباء بإزالة الحديد الزائد من الجسم. ولعلاج تكدس الحديد؛ قد يلجأ الاطباء الى وصف دواء سائلاً يعطى ببطء تحت الجلد، أو أحد أنواع حبوب منع الحمل.
يمكن استخدام عملية زرع الخلايا الجذعية لعلاج الثلاسيميا الشديدة.
• علاج تكدس الحديد:
يقوم الأطباء بإزالة الحديد الزائد من الجسم. ولعلاج تكدس الحديد؛ قد يلجأ الاطباء الى وصف دواء سائلاً يعطى ببطء تحت الجلد، أو أحد أنواع حبوب منع الحمل.
هل يؤثر مرض الثلاسيميا على الزواج؟
يمكن للأشخاص الذين يعانون من مرض الثلاسيميا، أن يتزوجوا بشكل طبيعي، وبإمكانهم إنجاب الأطفال، فمن الممكن أن يتمتع مريض “الثلاسيميا” بصحة إنجابية جيدة إذا التزم بالعلاجات المناسبة لحالته منذ بداية اكتشافه للمرض.
يمكن للأشخاص الذين يعانون من مرض الثلاسيميا، أن يتزوجوا بشكل طبيعي، وبإمكانهم إنجاب الأطفال، فمن الممكن أن يتمتع مريض “الثلاسيميا” بصحة إنجابية جيدة إذا التزم بالعلاجات المناسبة لحالته منذ بداية اكتشافه للمرض.
كما أنه عندما يتزوج حامل الثلاسيميا، ليس من الضروري أن ينقل هذا المرض إلى جميع أطفاله، فالزواج من شخص غير حامل للمرض، في كل حالة حمل، سيكون هناك احتمال بنسبة 50٪ أن يكون الطفل مصابًا بالثلاسيميا الخفيفة، مقابل 50٪ بأن يكون معافا.
وطرق تحليل الثلاسيميا:
- Complete blood count (CBC), which includes measures of hemoglobin and the quantity (and size) of red blood cells.
- Reticulocyte count (a measure of young RBCs) may indicate that your bone marrow is not producing an adequate number of red blood cells.
- Complete blood count (CBC), which includes measures of hemoglobin and the quantity (and size) of red blood cells.
- Reticulocyte count (a measure of young RBCs) may indicate that your bone marrow is not producing an adequate number of red blood cells.
- Iron studies. These may include: iron, ferritin, unsaturated iron binding capacity (UIBC), total iron binding capacity (TIBC), and percent transferrin.
- Hb electrophoresis is used to diagnose beta thalassemia.
- Genetic testing is used to make a diagnosis of alpha thalassemia
- Hb electrophoresis is used to diagnose beta thalassemia.
- Genetic testing is used to make a diagnosis of alpha thalassemia
جاري تحميل الاقتراحات...